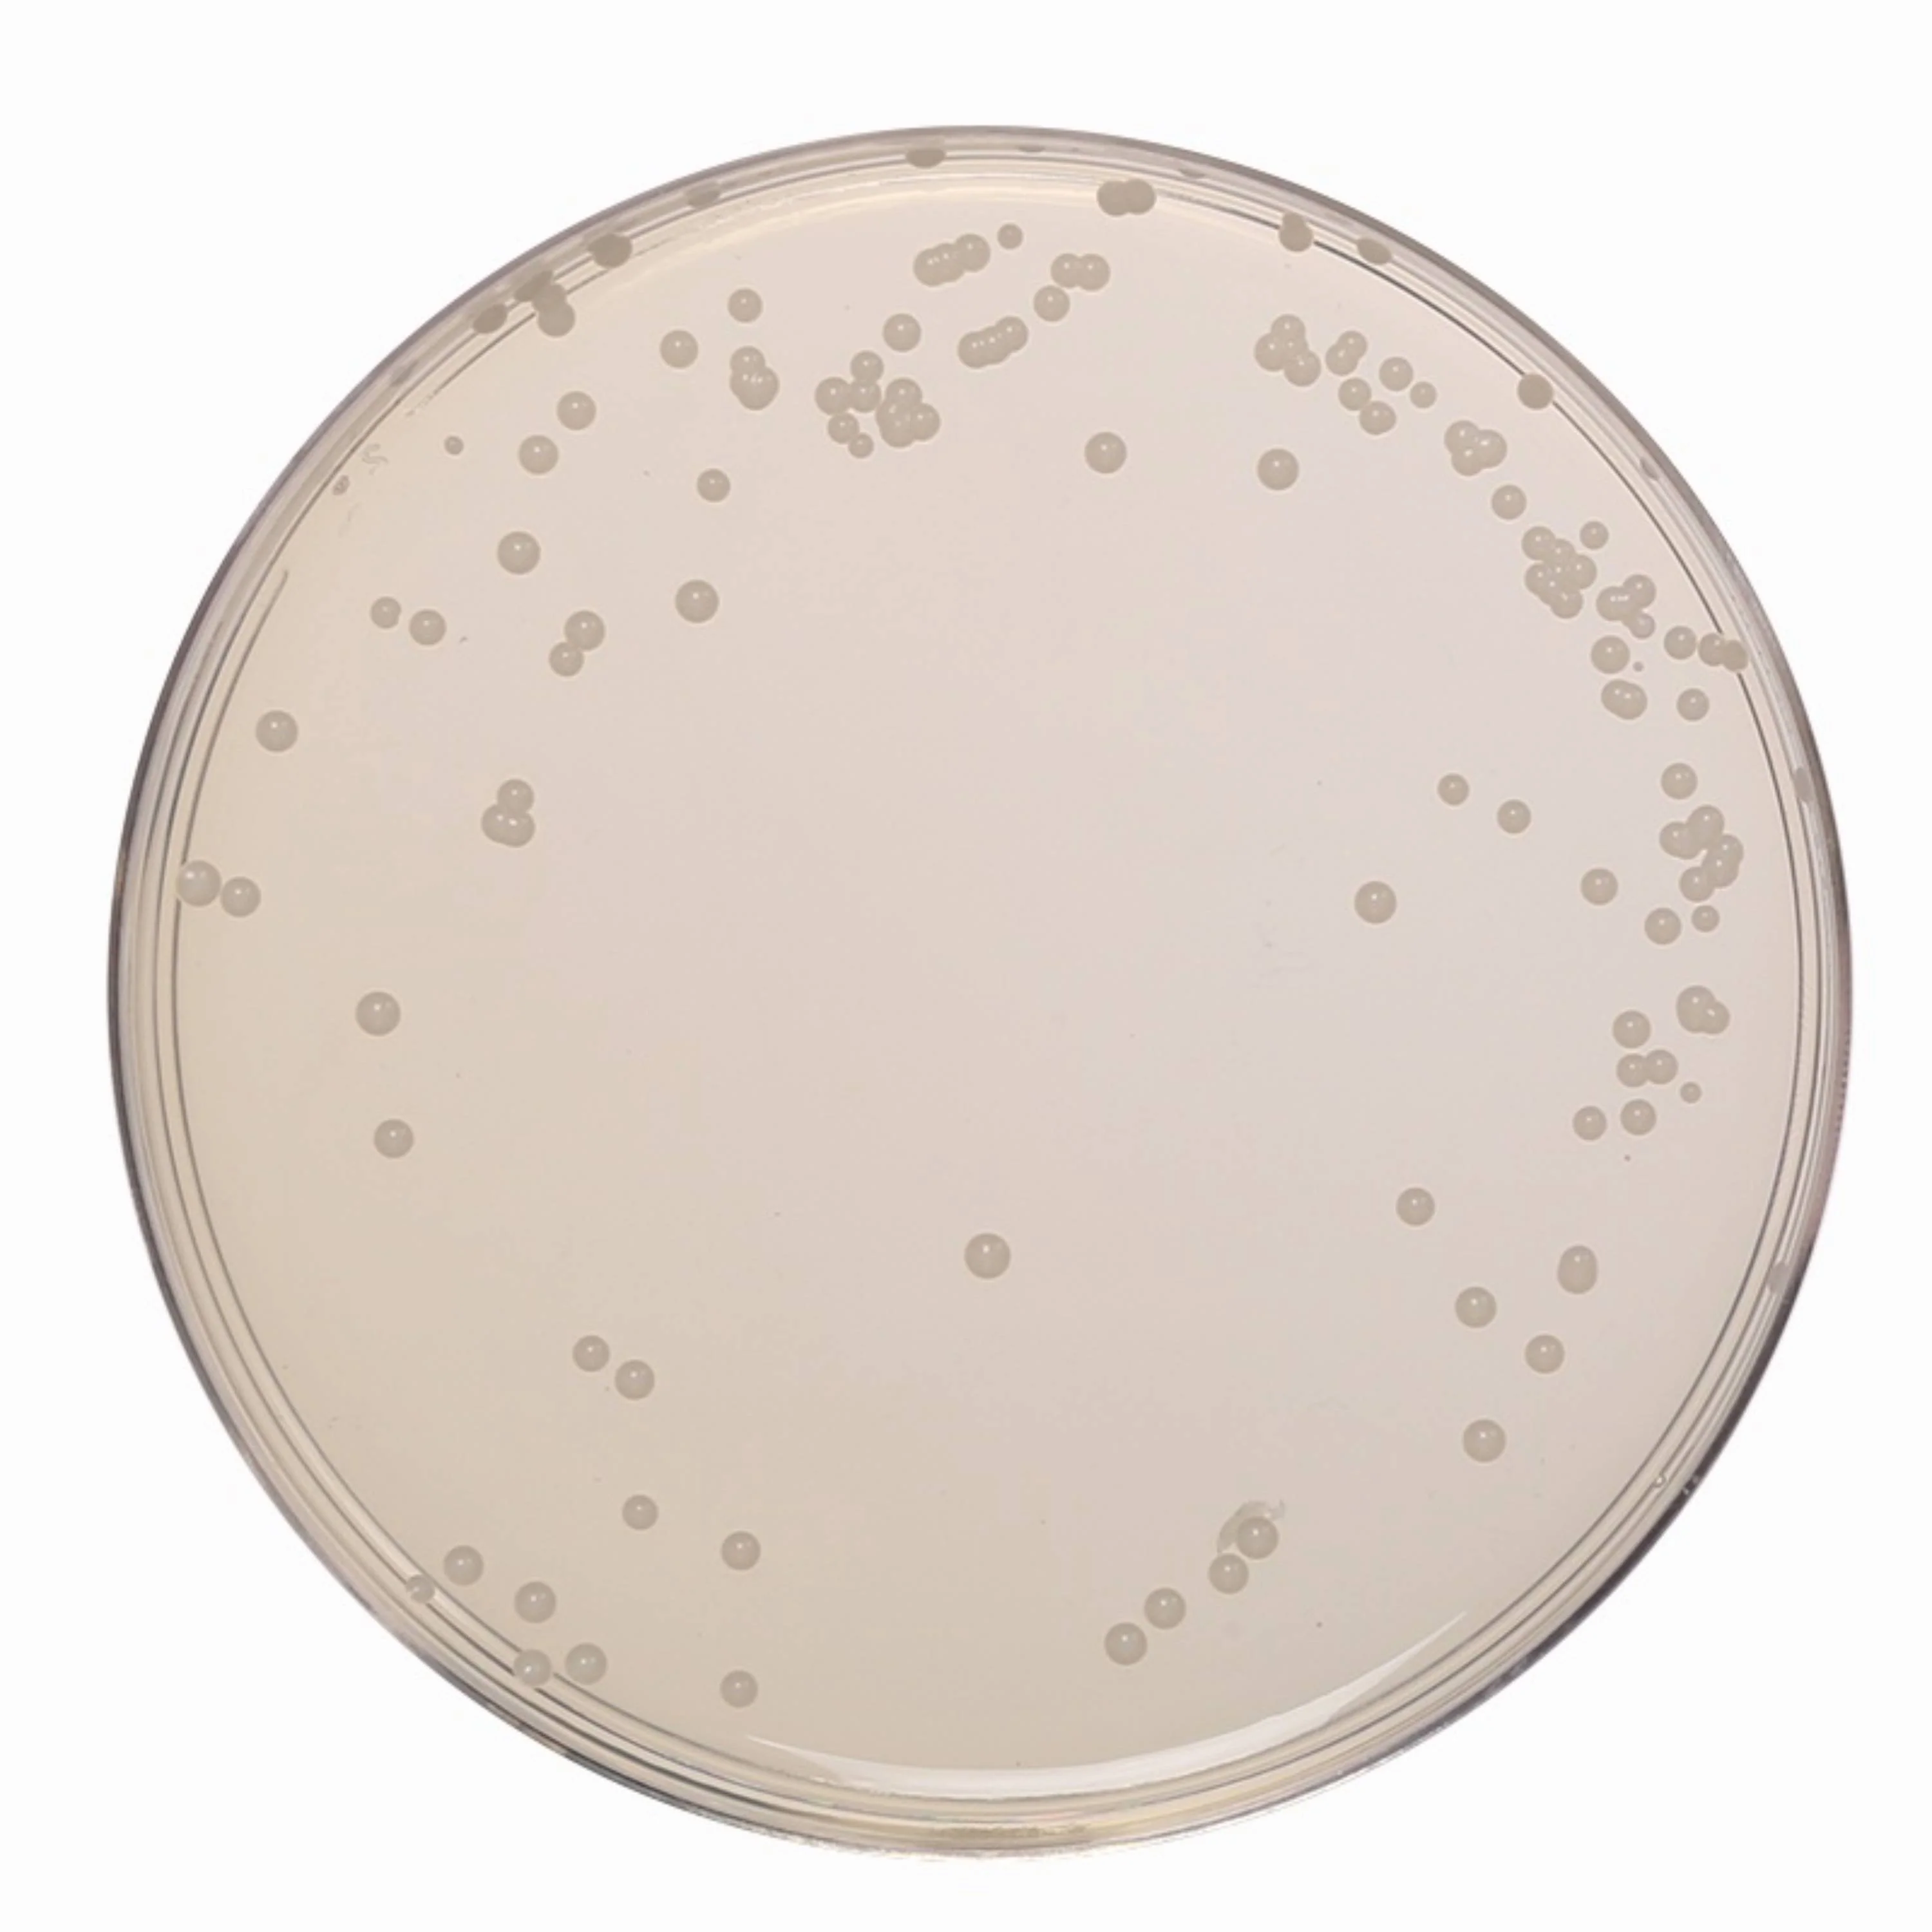
Thumbnail 2

✨ New Arrivals Just Dropped!Explore
Trending Now
Quality products, delivered with care.
Shop by Category
What Our Customers Say
★★★★★
“Amazing quality and fast shipping!”
S
Sarah M.
★★★★★
“Best store I have shopped at.”
J
John D.
★★★★★
“Exceeded my expectations!”
E
Emily R.
Our Features
🚚
Free Shipping
On orders over $50
🔒
Secure Payment
100% secure checkout
💬
24/7 Support
Always here to help
Ready to Get Started?
Join thousands of happy customers